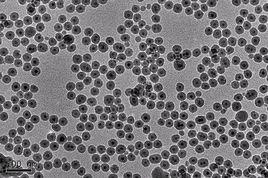
磁性納米粒子 磁性納米粒子

簡介
2015年2月,德國同步加速器(Deutsches Elektron-Synchrotron)的X-光研究結果顯示,磁性納米粒子能增加高聚物太陽能電池的性能。這個工作是由牧爾黑技術大學(Tecnical University of Munich)教授Peter Muller-Buschbaum領導的。
高聚物或有機太陽能電池具有許多優勢:便宜,柔軟和多種性能;缺點是比矽太陽能電池的效率低。典型的高聚物太陽能電池把太陽能轉換的效率為百分幾。但由於便宜,在一些情況下仍能存在使用,科學家也在尋找方法提高它的轉換效率。
一種可行的方法是加納米粒子;例如,加金納米粒子吸收附加的太陽光,多產生電荷載流子,使轉換效率提高。
Muller-Buschbaum研究組採用不同的辦法;他們認為,在太陽能電池中,產生帶正電和帶負電的成對電荷載流子,要在正,負電荷載流子複合之前將它們分開,後將它們向反方向電極流去。
電子自旋可分為+1/2和-1/2二種;二個電子可合為1或0的自旋。研究人員要找方法使二個電子為0的狀態轉為1狀態:這要求重元素的納米粒子;Fe3O4可適用於此種情況。在他們的實驗中,往聚合物太陽能電池中加入Fe3O4可使電池的效率增加到11%。
X-光研究結果顯示,如在太陽能電池材料中混入過多納米粒子,會使它的結構發生變化;如加入量為重量的1%時,它的結構不會變化。但加重量0.6%的納米粒子的效果最好;可使太陽能電池的效率從3.06增加到3.37%之間。這對某一特別使用來說,經濟效益是不錯的。
研究人員還相信,對其它高聚物,加入納米粒子也可增加其效率。但他們認為單用X-光作為研究工具,還不能了解為何加入納米粒子到高聚物內會使太陽能電池效率提高的具體機制。
磁性納米粒子/磁性納米顆粒(Magnetic Nanoparticles, MNPs)是近年來發展迅速且極具套用價值的新型材料,在現代科學的眾多領域如生物醫藥、磁流體、催化作用、核磁共振成像、數據儲存和環境保護等得到越來越廣泛的套用。
研究人員、工程師、化學家和物理學家的共同努力下,納米技術使得生命科學和健康醫療領域在分子和細胞水平上取得很大的進展。磁性納米粒子是納米級的顆粒,一般由鐵、鈷、鎳等金屬氧化物組成的磁性核心及包裹在磁性核心外的高分子聚合物/矽/羥基磷灰石殼層組成。最常見的核層由具有超順磁或鐵磁性質的Fe3O4或γ-Fe2O3製成,具有磁導向性(靶向性),在外加磁場作用下,可實現定向移動,方便定位和與介質分離。最常見的殼層由高分子聚合物組成,殼層上偶聯的活性基團可與多種生物分子結合,如蛋白質、酶、抗原、抗體、核酸等,從而實現其功能化。因此磁性納米粒子兼具磁性粒子和高分子粒子的特性,具備磁導向性、生物兼容性、小尺寸效應、表面效應、活性基團和一定的生物醫學功能。
由於其獨特的物理、化學特性,磁性納米粒子可以簡化繁瑣複雜的傳統實驗方法,縮短實驗時間,是一種新型的高效率的試劑。目前,磁性納米粒子在生物醫藥方面主要套用在磁性分離、磁性轉染、核酸/蛋白質/病毒/細菌等的檢測、免疫分析、磁性藥物靶向、腫瘤熱療、核磁共振成像和感測器等。下文將具體介紹磁性納米粒子的性質及在生物醫學領域的主要套用, 並列出對應於不同套用的具體產品。
性質
磁性納米粒子有一系列獨特而優越的物理和化學性質。隨著合成技術的發展,已成功生產出一系列形狀可控、穩定性好、單分散的磁性納米粒子。
磁性納米粒子具有的磁性使其易於進行富集和分離,或進行定向移動定位。磁效應由具有質量和電荷的顆粒運動形成。這些顆粒包括電子、質子、帶正電和負電的離子等。帶電顆粒旋轉產生磁偶極,即磁子。磁疇指一個體積的鐵磁材料中所有磁子在交換力的作用下以同一方向排列。這個概念將鐵磁與順磁區別開來。
鐵磁性材料有自發磁化強度,在無外加磁場時,也具有磁性。鐵磁材料的磁疇結構決定磁性行為對尺寸大小的依賴性。當鐵磁材料的體積低於某個臨界值時,即成為單磁疇。這個臨界值與材料的本徵屬性有關,一般在幾十納米左右。極小顆粒的磁性來源於基於鐵磁材料磁疇結構的尺寸效應。這個結論的假設是鐵磁顆粒在具有最低自由能的狀態對小於某個臨界值的顆粒有均勻的磁性,而對較大顆粒的磁性不均勻。前者較小顆粒稱為單磁疇顆粒,後者較大的顆粒稱為多磁疇顆粒。
當單磁疇顆粒的直徑比臨界值更進一步降低,矯頑力變成零,這樣的顆粒即成為超順磁。超順磁由熱效應造成。超順磁納米粒子在外加磁場作用下具有磁性,而在外加磁場移除後不具有磁性。在生物體內,超順磁顆粒只在有外加磁場時具有磁性,這使得它們在生物體內環境中具有獨特優點。鐵、鈷、鎳等晶體材料都有鐵磁性,但由於氧化鐵磁鐵(Fe3O4)是地球上天然礦物中最具磁性的,且生物安全性高(鈷和鎳等材料具有生物毒性),因而在多種生物醫學套用中,超順磁形式的氧化鐵磁性納米粒子最常見。
鐵磁流體(磁流體)是在外加磁場作用下變得具有很強磁性的液體,它是既具有磁性又具有流動性的新型功能材料。鐵磁流體是由納米級的鐵磁或亞鐵磁構成的膠體溶液,顆粒懸浮於載體溶液中,載體溶液通常為有機溶劑或水。納米顆粒完全被表面活性劑包裹以防止聚合成團。鐵磁流體通常在無外加磁場時不保持磁性,因而被歸類為超順磁。鐵磁流體中的納米粒子在正常條件下由於熱運動不發生沉降。
球形顆粒的磁性納米粒子的比表面積(表面積與體積之比)與直徑成反比。對於直徑小於0.1um的顆粒,其表面原子的百分數急劇增大,此時表面效應顯著。顆粒直徑減小,比表面積顯著增大,同時表面原子數迅速增加。當粒徑為1nm時表面原子數為完整晶粒原子總數的99%,此時構成納米粒子的幾乎所有原子都分布在表面上,在表面原子周圍形成很多懸空鍵,具有不飽和性,易與其他原子結合形成穩定結構,表現出高化學活性。因此,固定目標分子/原子效率高。
磁性納米粒子與多種高分子具有良好的生物兼容性。 磁性納米粒子的表面修飾包括:非聚合物有機固定、聚合物有機固定、無機分子固定、靶向配套修飾等。常用來作為修飾的物質有聚乙二醇、葡聚糖、聚乙烯吡咯烷酮、脂肪酸、聚乙烯乙醇、多肽、明膠、殼聚糖、甲基矽烷、脂質體等。磁性納米粒子的表面修飾主要有2種途徑:一是表面修飾材料與粒子表面依靠化學鍵結合,這通常是指一些有機小分子化合物;二是用有機或無機材料直接包裹磁性納米粒子,主要包括表面活性劑、高分子聚合物、貴金屬和二氧化矽等。表面修飾不僅增強了磁性納米粒子的穩定性,還能提高其在水溶液中的分散性和生物相容性,提高靶向性,防止蛋白吸附,增加其在血液循環中的時間,以及進一步複合其它的納米粒子、化合物或生物配體,實現磁性納米粒子的功能化。
套用
磁性納米粒子在生物醫學方面的套用主要分為兩大類:體外套用主要包括分離純化、磁性轉染、免疫分析、催化、Magnetorelaxometry、固相萃取等。體內套用可大致分為治療和診斷兩類,治療方面的套用如熱療和磁靶向藥物(targeted medicine),診斷方面的套用如核磁共振成像(NuclearMagentic Resonance, NMR)。
體外套用
生物分離和純化是生物和醫藥技術中最重要的技術之一。這也是磁性粒子套用中最具成果的一種。磁性分離方法具有高效、簡單、快速的優點。磁性粒子可用於蛋白質、核酸等生物分子和細胞的分離,核酸的分離純化是用納米級的磁性粒子。
在生物分離上,磁性納米粒子體積小、表面積大,具有分散性好,可快速有效的結合生物分子,並且這種結合是可逆的,另外絮團形成可以被控制,因而使用磁性納米粒子進行分離優於使用微米級樹脂和珠子的傳統方法。大多數分離用的磁性納米粒子是超順磁的-在無外加磁場時,粒子無磁性,均勻懸浮在溶液中,而當使用外加磁場時,粒子具有磁性可被磁分離。磁性納米粒子表面連線的具有生物活性的吸附劑或其他配體等活性物質可與特定生物分子或細胞特異性結合,在外加磁場作用下分離。磁性分離方法基本只包括2個步驟:1.用磁性納米粒子標記目標分子或細胞;2. 通過磁分離裝置分離出目標分子或細胞。利用磁性納米粒子分離的例子之一是把特異性抗體與磁性納米粒子結合,可將磁性納米粒子連線在特定細胞上,外加磁場即可快速將結合磁性納米粒子的細胞分離或進行免疫分析。這樣的方法特異性高、分離迅速、重現性好。又如,將葡萄糖-DEAE包裹在磁性納米粒子表面,利用帶正電荷的DEAE與帶負電荷的核酸之間的電荷吸附作用,通過離子交換,在細菌裂解上清中提純質粒。
磁性轉染
是將結合有載體DNA的磁性納米粒子在外界磁場影響下轉染到細胞內的方法。用於磁性轉染的磁性粒子多用多聚陽離子、多聚氮雜環丙烷進行表面修飾。由於它們帶有陽性電荷,易於與帶有陰性電荷的DNA結合,與利用病毒或非病毒載體的轉染相比,轉染效率提高几十到幾千倍。磁性轉染還具有轉基因表達提高,使用極低劑量的載體既可獲得高轉染率和高轉基因表達,使用方法簡單等優點。磁性轉染方法已成功用於多種類型的貼壁細胞及少數懸浮細胞,包括難以用常規方法轉染的原代細胞、腫瘤細胞等。德國Chemicell公司生產的MagnetofectionTM磁性轉染試劑被很多世界頂級的實驗室選用,並有多篇文章發表。
免疫分析是現代生物分析技術中重要的一種方法,利用它可對蛋白質、抗原、抗體及細胞進行定量分析。例如在免疫檢測中,經常用一些具有特殊物理化學性質的標記物如放射性同位素、酶、膠體金和有機螢光染料分子等對抗體(或抗原)進行偶聯標記,在抗原、抗體識別後,通過對標記物的定性或定量檢測而達到對抗原(或抗體)檢測的目的。由於磁性納米粒子具有超順磁性,為樣品的分離、富集和提純提供了很大方便,在免疫檢測方面受到廣泛關注。
近年來,用磁性納米粒子支持催化劑被廣泛用來改善催化不均一的問題。磁性分離使在液相反應中回收催化劑比用橫流式過濾和離心方法更容易,特別是催化劑在亞微米級範圍內時。如此小並且可被磁性分離的催化劑兼具高分散性和反應性及易分離的優點。在回收利用昂貴的催化劑或配體方面,用磁性納米粒子固定這些活性物質使得在準同質系統中分離催化劑變得簡單。 近年來出現的將催化位點移植到磁性納米粒子上進行不同類型的過渡金屬催化的反應包括碳-碳交聯反應、烯烴醛化反應、氫化作用、聚合反應等。已報導的磁性納米粒子支持的催化劑包括酶、水解酯的胺基酸、促進Knoevenagel反應和相關反應的有機胺催化劑等。
磁粘度
移除磁場後磁性納米粒子系統的淨磁矩。有2種不同的弛豫機制:尼爾弛豫和布朗弛豫,這兩種機制的區別在於弛豫時間不同。另外,布朗弛豫只在液體中發生,然而尼爾弛豫不依賴於納米粒子的分散性。
Magnetorelaxometry由核大小、水合直徑和各向異性決定的現象使得這個技術可以用於根據游離的和結合的結合物磁性行為不同區分其狀態是游離的還是結合的,因此這個技術可作為評估免疫檢測的分析工具。
Magnetorelaxometry最初被用來評估免疫檢測,它可以用於體外或體內研究。Magnetorelaxometry可定量分析磁性納米粒子在器官或整個動物體內的分布,由於此方法是非侵入性的,因而可長期監測動物,例如監測磁標記的幹細胞,另一個例子是癌症(cancer)診斷。近年來出現的使用功能化的磁性納米粒子的磁弛豫免疫分析(MagneticRelaxation Immunoassay,MARIA)基於這個物理學方法。磁弛豫免疫分析技術的優點是:結合的粒子和游離的粒子產生不同信號,與傳統方法不同,不需洗滌步驟;不需要標記物;每個檢測的時間極短,因而可用於高通量實驗;由於磁弛豫可在不透光的介質中被檢測,因而也可用於體內實驗;磁性納米粒子與基於用高靈敏度的磁場感測器如SQUID(SuperconductiveQuantum Interference Device)檢測磁弛豫的技術結合,可獲得高靈敏度。在這個套用上,與分離純化同理,也是納米級的粒子優於微米級的粒子。
目前,固相萃取(Solid-Phase Extraction,SPE)作為從樣品中分離和預濃縮目標成分受到很多關注。固相萃取是從環境樣品中檢測痕量污染物的常規方法。近來,納米級顆粒在樣品提取方面的套用獲得快速和長足的發展。固相萃取與傳統的樣品富集方法(如液相抽提)相比,是很好的替代方法。當從大體積樣品中分離和預濃縮目標成分時,使用標準純化柱的固相萃取方法非常費時。因而使用磁性或可磁化的吸附劑的磁性固相萃取(MagneticSolid-Phase Extractin,MSPE)越發重要。在這個過程中,在含有目標成分的溶液或懸浮液中加入磁性吸附劑。然後,利用合適的磁分離裝置,將吸附了目標成分的磁性吸附劑回收。
在環境科學方面,近年來進行了用磁性納米粒子去除有機和無機污染物的研究,並且用它們去除地下水、土壤和空氣中污染物的實驗已在實驗室和實地規模上使用。高濃度的有機污染物大多為染料。織染工廠、顏料工廠、製革廠等的廢水中均含有染料。用磁性納米粒子替代昂貴或低效的吸附劑可成為一種好的平台,但這仍需要更多的研究。去除無機污染物的一個主要方面是去除金屬毒素。磁性納米粒子作為從複雜基質中去除金屬毒素的吸著劑具有高容量和高效率的優點,由於體積小,表面積大,比微米級吸著劑更好。這些發現有助於設計更好的從廢水中去除或回收金屬離子的吸附處理計畫。另外,還可利用功能化的磁性納米粒子對環境樣品中細菌、真菌等微生物進行分離和檢測。
體內套用
影響體內套用的磁性納米粒子的2個主要特性是大小和表面功能。超順磁氧化鐵納米顆粒(Superparamagnetic Iron Oxide,SPIOs)的直徑對它們在體內的生物分布有很大影響。直徑為10-40nm的顆粒包括超小的超順磁氧化鐵納米顆粒可以在血液循環中滯留較長時間,它們可以通過毛細血管壁,並常被去往淋巴結和骨髓的巨噬細胞所吞噬。
熱療是指將超順磁氧化鐵置於交流電磁場中,可使磁方向在平行和反平行之間隨機變換,使磁能以熱的形式傳遞給顆粒,在生物體內這個特性可用來破壞病態細胞。腫瘤細胞比健康細胞對溫度更敏感。研究顯示磁性陽離子脂質體納米顆粒和葡聚糖包裹的磁鐵在細胞輻射的熱療中有效的增高了腫瘤細胞的溫度。這種方法被認為是未來癌症(cancer)治療的主要方法。磁熱療的優點是溫度升高僅局限於腫瘤區域。此外,亞疇磁性顆粒(納米級)比多疇磁性顆粒(微米級)更優,因為它們在機體可承受的交流電磁場中能吸收更多的能量,這是它們的大小和形狀決定的。因此,明確的可生產顆粒均勻的合成路徑對於溫度的嚴格控制很關鍵。
藥物靶向成為現代給藥技術之一。磁性納米粒子與外加磁場和/或可磁化的植入物可將顆粒遞送到靶標區域,在藥物釋放時使顆粒固定在局部位點,因而藥物可在局部釋放。這個過程稱為磁性藥物靶向(MagneticDrug Targeting, MDT)。近來,使用氧化鐵磁性納米粒子靶向給藥的可行性越來越大。核心使用Fe3O4的磁性納米粒子的直徑小、靈敏度高、毒性低、性能穩定、原材料易得。 Fe3O4一般對人體不產生毒副作用,整個療程所用的載體含鐵量不超過貧血病人的常規補鐵總量,除部分被人體利用外,其餘的磁性粒子能通過皮膚、膽汁、腎臟等安全排出體外。納米顆粒表面修飾的有機聚合物或無機金屬或氧化物使它們具有生物兼容性,並適合連線具有生物活性的分子從而具有功能性。將藥物遞送到特定位點可消除藥物的副作用,並降低用藥劑量。
磁性納米粒子在體內診斷方面的套用主要用於核磁共振成像。由於核磁共振成像在診斷上的發展,出現了一類新型藥物-磁性藥物。這些藥物給病人服用後的主要用途是提高正常和患病組織的對比度(造影劑)和/或顯示器官功能或血流情況。超順磁氧化鐵納米粒子在體外和體內細胞和分子成像中成為一類新的探針。在核磁共振中使用超順磁顯影劑具有產生比順磁的顯影劑更強的質子弛豫的優點。因而,需要注射到體內的顯影劑劑量更少。然而,核磁共振不便於進行原位監測。
磁性納米粒子在生物醫學領域已表現出獨特的優勢,目前對於它們在此領域的套用仍在快速增長。磁性納米粒子在生物醫學領域及其他領域必將發揮更大的作用。
德國Chemicell公司生產多種磁性納米粒子,磁性納米微粒子,螢光納米粒子,螢光微粒子等, 適用於多種生物醫學方面的套用。北京啟維益成科技有限公司代理Chemicell公司的所有產品。Chemicell的部分磁性納米粒子產品及套用見下表。
參考文獻:
1. Akbarzadeh A., Samiei M.,Davaran S. Magneticnanoparticles:preparation, physical properties, and applications inbiomedicine. Nanoscale Research Letters 2012, 7:144
2. 趙子凱,惠國華,陳裕泉. 納米磁珠材料的製備及在生物醫學領域的套用進展.國際生物醫學工程雜誌2009,Vol.32,No.3: 183-186
3. 王偉,吳堯,顧忠偉.磁性納米粒子的表面改性及其在生物醫學領域的套用. 中國材料進展2009,Vol.28 No.1:43-48
4. 錢俊臻,萬巧鈴,黃紅稷.磁性納米粒子的製備及其在分離檢測上的套用.四川理工學院學報2007,Vol.20 No.3:51-56
5. 趙強,龐小峰. 磁性納米生物材料研究進展及其套用.原子與分子物理學報2005,Vol.22 No.2:222-225
6. 王晶,徐玉清,王文秀. 磁性納米粒子及其在生物醫學中的套用進展2007,14(5):386-390